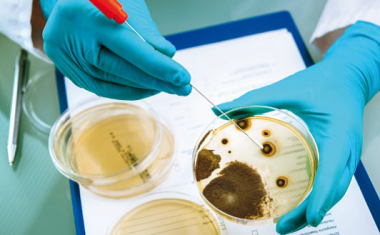
Photo

31.05.2016 • Themen • Technologie





Die Firma Gempex, das GMP-Dienstleistungsunternehmen für die Life Science Industrie aus Mannheim, begleitet Hersteller und Zulieferer bei der Einführung, Optimierung und Aufrechterhaltung von Qualitätssicherungssystemen.



Seit Ende Oktober 2015 weht der Richtkranz über dem künftigen Produktionsgebäude am Stammsitz der Firma Biotest in Dreieich.